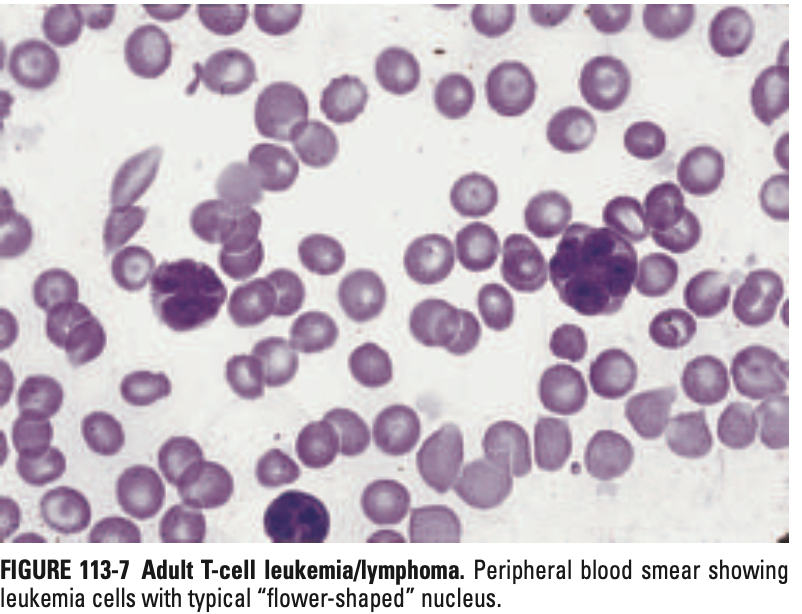

비호지킨 림프종
비호지킨 림프종
정의
림프구(B, T, NK 세포)에서 기원하는 림프계의 악성 종양으로, 호지킨 림프종을 제외한 모든 림프종을 포함
검사 및 평가
신체진찰, B 증상 확인
CBC, LFT, 요산, 칼슘, 혈청 단백질 전기영동 검사, 혈청 B2 microglobulin
영상검사: CXR, CT
CSF 검사: ALL, Burkitt’s lymphoma, DLBCL
SPECT/PET-CT : large cell lymphoma
조직검사
진단 및 병기
필수 검사: 조직 생검, 면역표현형 검사, FDG-PET/CT(공격성)
병기: Ann Arbor Staging System (I-IV기)
병기설정
예후 예측: IPI (International Prognostic Index)
- 연령(>60), LDH(증가), 수행상태(≥2), 병기(III/IV), 림프절 외 침범(>1)
말초 T세포 림프종 (PTCL)
B세포 NHL보다 드물고 예후 불량
1차 치료: CHOP 기반 요법. CD30+인 경우 Brentuximab vedotin 포함 요법
[1] Harrison 22e, pg. 857-868
Mature B-cell Lymphoma
[Indolent types]
CLL/SLL → CLL 단원 참고
면역조직화학염색
양성: CD5, CD19, CD20(dim), CD23
Follicular lymphoma (FL)
면역조직화학염색
양성: CD19, CD20, CD10, BCL6
음성: CD5, CD23
t(14;18)의 존재, BCL2의 비정상 발현 시 확진
조직소견 : 정상 nodal architecture가 종양세포로 인해 넓어진 모습
치료
무증상: 경과관찰
유증상: 치료 시작 (Rituximab ± Bendamustine/CHOP/CVP/lenalidomide)
Grade 3 or DLBCL 로의 전환
treatment naive: R-CHOP (DLBCL에 준하여 치료)
previously treated: extensive combination CTx → autologous HSCT
Marginal Zone lymphoma (MZL)
Nodal MZL
CD 19+ , CD 20+, CD 79a + / CD 10 -, CD 5 -
치료: FL과 유사, BTK inhibitor (Ibrutinib, zanubrutinib) 효과적
Splenic MZL
Rituximab 기반 치료, splenectomy
Extranodal MZL of MALT (MALToma)
만성 염증성 자극에 의해 발생 (위, 침샘, 결막, 갑상샘 등)
CD 19+ , CD 20+, CD 79a + / CD 10 -, CD 5 -
t(11;18), t(14;18), t(1;14), t(3;14), trisomy 8 과 연관
대부분 무증상, 원인이 치료되는 경우 자연 호전
Stage I/II 의 경우 RT 가 효과적
Mantle cell lymphoma (MCL)
특징 면역화학염색: t(11;14) → Cyclin D1 overexpression
CD5+, cyclin D1 +, CD19+, CD20+ / CD 23-, CD 10-
치료
무증상/진행느린 변이형: 증상 발현/장기기능장애 시점까지 경과관찰
국소성 질환: 복합항암요법 → 방사선 치료
전신성 질환(m/c): 복합항암화학요법 치료 관련 연구가 현재진행형
고강도요법 (R-CHOP + HD cytarabine ± Autologous HSCT)
BR (Bendamustine + Rituximab) ± cytarabine/Ibrutinib 등
Lymphoplasmacytic lymphoma (LPL)
림프형질세포(Lymphoplasmacytic) 분화를 보이는 B세포 NHL, paraproteinemia 동반
핵심 유전학: MYD88 활성 돌연변이
치료 적응증: 증상/장기기능 장애 유발시
hyper viscosity syndrome: plasmapheresis
Low-volume: Rituximab 단독
Active: BR, / Highly active: Rituximab + Ibrutinib/Zanubrutinib
[Agressive types]
Burkitt’s lymphoma (BL)
특징
소아 NHL 의 30% 차지
매우 빠르게 성장 (종양 doubling time <24hr)
35세 미만, 남성에서 호발
임상양상
풍토병형(Endemic/아프리카형): 턱 또는 안면골 종양으로 발생, EBV 양성
비풍토병형 (Nonendemic): 복부 종괴로 발현, EBV 대부분 음성
면역결핍 연관형: 주로 림프절 침범
조직소견: 고전적인 “Starry sky” appearance
면역표현형: CD 19 +, CD 20 +, CD 10 +, BCL 6 + / BCL2 -
유전자: MYC translocation (>95%)
치료: 즉각적인 치료 시작, 고강도 복합화학요법 (EPOCH-R), CNS 예방 요법
Diffuse Large B-cell lymphoma (DLBCL)
가장 흔한 NHL 아형
표준 치료: R-CHOP / Polatuzumab + R-CHP (IPI 2점 이상)
재발/불응성: 2차 치료로 CAR-T 세포 치료 또는 ASCT
Mature T-cell Lymphoma
[Non cutaneous]
Peripheral T-cell lymphoma (PTCL)
임상양상
진단 시 병기: 대부분 진행성 병기 (Advanced-stage)
주요 침범 부위: 골수, 간, 비장, 피부 (흔함)
주요 증상: "B" 증상, 가려움증 (Pruritis)
동반 소견:
반응성 호산구증가증 (Reactive eosinophilia)
혈구탐식증후군 (Hemophagocytic syndrome)
면역표현형
CD3+ (T세포)
대부분 CD4+ (CD8- 보다) / 일부는 CD4-/CD8- (Double negative)
예후 불량 인자: 성숙 T세포 표지자(CD5, CD7) 소실
유전학:
TCR 유전자 관련 재발성 전위 (t(7;14), inv(14) 등)
치료
1차치료: CHOP 기반 치료 ± etoposide, brentuximab (CD30+)
공고요법: ASCT
Angioimmunoblastic T-cell lymphoma (AITL)
주요 증상: 림프절병증, 간비장비대, "B" 증상, 발진, 다발성 관절염, 용혈성 빈혈
진단 시 병기: > 80%가 진행성 병기, 골수 침범 흔함
검사 소견: 다클론성 고감마글로불린혈증 (흔함), LDH 상승, Eosinophilia, 쿰스 검사 양성
CD4+, CD3+, CXCL13+, PD-1+, CD10+, BCL6+
치료: CHOP 기반 복합항암화학요법
Anaplastic Large cell lymphoma (ALCL)
소아 호발 (소아 림프종의 10% 차지)
핵심 분류
ALK 양성: t(2;5) -> NPM1-ALK 융합 유전자, 젊은 나이 발생, 예후 양호
ALK 음성: 고령 환자, 예후 불량
병리 소견: 말굽모양핵 (Horseshoe shaped nucleus)
면역표현형: CD30+ , CD15 - , CD 3+, CD25+ , CD43+, CD4+
치료: CHOP + etoposide (ALK+)/ Brentuximab (CD30+)
Adult T-cell leukemia/lymphoma (ATLL)
특징: HTLV-1 바이러스에 의해 유발, 매우 빠르게 진행, 1년 이내 사망률 높음
임상양상: 순환 종양세포 및 골수 침범, 고칼슘혈증, Lytic bone lesion, 림프절병증, 간비장비대, 피부병변, 기회감염
병리소견: 꽃잎세포 (pathognomonic)
면역표현형
양성: CD4+, CD25+ (매우 특징적), CD2+, CD3+, CD5+
음성: CD7-
치료: 복합항암화학요법, 항레트로바이러스제 등
Extranodal NK/T cell lymphoma
주변 조직을 파괴하는 비인두 종양으로 발현
EBV 감염과 강하게 연관 (CD21 -), T cell receptor rearrangement 소실
조직소견: 작은 혈관을 둘러싸고 침범하는 종양세포, 광범위한 허혈성 조직괴사
치료
국소병기: CCRT (Etoposide, Ifosfamide, Cisplatin, Dexamethasone)
진행성 병기: SMILE 요법 (Dexamethasone, Methotrexate, Ifosfamide, L-asparaginase, Etoposide)
[Cutaneous]
Mycosis Fungoides
초기 증상: 진단 수년 전부터 습진(eczematous) 또는 피부염(dermatitic) 유사 병변 발생
림프절 침범, 내부장기 침범 가능
세자리 증후군 (Sézary’s syndrome): 전신 홍피증(generalized erythroderma) + 순환 종양 세포 발생
치료
국소성 초기: 방사선치료 (전신 피부 전자선 조사, TSEB)
진행성 질환 (고식적 치료): 국소 스테로이드, 광선치료, 전신치료 (Bexarotene, IFN, HDAC, 항암치료, Mogamulizumab)
연습문제 16문제
0/16 완료
0개의 글
** 제목만 보더라도 어떤 내용인지 알 수 있도록 완성된 문장으로 작성해주세요.
예시) 초음파 (X) → 초음파 사진에서 PDA 소견을 어떻게 알 수 있나요? (O)